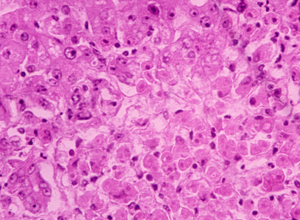

從陰道鏡檢查結(jié)果來(lái)看,兩者并沒(méi)有太大的區(qū)別,最終導(dǎo)致的結(jié)果也是相同的。媽媽的變化:孕期時(shí)應(yīng)盡量選擇淋浴,避免坐浴或盆浴,以免臟水進(jìn)入陰道引起感染。媽媽的變化:在孕期,盡量選擇淋浴,避免坐浴或盆浴,以免臟水進(jìn)入陰道導(dǎo)致感染。

TCT檢查結(jié)果可分為多種類(lèi)型,根據(jù)結(jié)果可能需要進(jìn)一步進(jìn)行陰道鏡下宮頸活檢確診。寶寶變化:我開(kāi)始變胖了,在媽媽的肚子里變大了,我皺巴巴的皮膚變得舒展了!媽媽變化:孕期盡量選擇淋浴,不要坐浴或盆浴,以免臟水進(jìn)入陰道造成感染。
寶寶的變化:我在媽媽的肚子里變得更大更胖了,我皺巴巴的皮膚也變得舒展了!媽媽的變化:在孕期,選擇淋浴,不要坐浴或盆浴,以免臟水進(jìn)入陰道,引發(fā)感染。不同之處在于后續(xù)的復(fù)查,位患者的HPV16呈陽(yáng)性,TCT呈陰性,這種情況需要進(jìn)行陰道鏡檢查;而如果HPV58呈陽(yáng)性,TCT呈陰性,則不需要進(jìn)行陰道鏡檢查。
寶寶的變化:我在媽媽的肚子里長(zhǎng)大了,皮膚也變得舒展了呢!媽媽的變化:懷孕期間,選擇淋浴,不要坐浴或盆浴,以免臟水進(jìn)入陰道造成感染。如果這兩位女性感染的是同一型號(hào)的HPV,那么她們之間的差距有多大呢?從陰道鏡檢查結(jié)果來(lái)看,兩人的病變等級(jí)都是二級(jí),程度相當(dāng),其中一位是16型,另一位是58型。
寶寶的變化:我在媽媽的肚子里長(zhǎng)大了,變得更胖了,原來(lái)皺巴巴的皮膚現(xiàn)在也變得更加舒展了呢!\u003e媽媽的變化:孕期期間要盡量選擇淋浴,避免坐浴或盆浴,以免臟水進(jìn)入陰道引起感染。

甲硝唑片和甲硝唑栓所含的成分是一樣的,都含有甲硝唑,而在治療方面效果都很好。甲硝唑栓主要是在使用方法方面不一樣,甲硝唑栓只能用于陰道內(nèi)塞,不能口服。針對(duì)細(xì)菌性陰道炎,可以使用甲硝唑栓,每晚一粒...

大家好,今天跟大家分享一下蟲(chóng)草花有什么功效。蟲(chóng)草花既有補(bǔ)腎陰的作用,又補(bǔ)腎陽(yáng)的作用。所以蟲(chóng)草花這一根花體現(xiàn)了雙層作用,可以多燉點(diǎn)湯喝。蟲(chóng)草花該怎么食用呢?它有什么作用呢?蟲(chóng)草花對(duì)我們的身體有...

這到底怎么回事呢?我們接著往下看。腳趾甲疼不能按是怎么回事腳趾甲疼不能按可能是甲外傷、嵌甲、甲溝炎等引起的。指甲根部一按就疼痛是怎么回事指甲根部一按就疼痛可能是甲溝炎、嵌甲、甲下血管...

也就是在這個(gè)過(guò)程當(dāng)中不要乘坐飛機(jī),因?yàn)榕聝蓚€(gè)鼻孔都堵住了,怕到時(shí)候出現(xiàn)中耳炎、耳朵,出現(xiàn)一些其他的問(wèn)題。如果孩子已經(jīng)感冒發(fā)燒、患有急性鼻炎或急性中耳炎等疾病,避免乘坐飛機(jī)。有人想過(guò)坐飛機(jī)會(huì)...

腸腔是一個(gè)空腔臟器,里面有很多氣體,B超對(duì)含氣的這些器官不太適用,除非腸腔里邊有很大的腫瘤,讓這個(gè)空腔的腸腔變成了相對(duì)實(shí)性的器官,這時(shí)才有可能被B超發(fā)現(xiàn)。還有一種肌肉主要分布在身體空腔臟器和各...

所以如果只是一味使用桉油醇,反而會(huì)讓喉嚨越來(lái)越干。十滴水能祛痘,這事兒靠譜嗎?十滴水是什么?它是一種祛暑劑,由樟腦、干姜、大黃、小茴香、肉桂、辣椒、桉油等組成,具有健脾、祛暑的功效。因?yàn)檎骋旱?..

以上就是貧血的幾種主要類(lèi)型及其癥狀。貧血?經(jīng)常拿到報(bào)告單不懂看自己是否貧血?屬于哪種類(lèi)型的貧血?那就看過(guò)來(lái)咯。下面,我們將詳細(xì)介紹貧血的各種類(lèi)型及其癥狀。跟缺鐵性貧血說(shuō)再見(jiàn)!貧血有很多種類(lèi)型...
膽汁淤積不僅會(huì)損害肝細(xì)胞,還會(huì)導(dǎo)致肝臟炎癥和肝細(xì)胞壞死,甚至導(dǎo)致肝癌。丹參丹參能抑制和減輕急慢性肝損傷,肝細(xì)胞變性壞死以及炎癥反應(yīng)。肝細(xì)胞無(wú)法將膽汁排泄到腸道,導(dǎo)致膽汁淤積。...

彩椒木耳炒牛肉,喜歡吃,白灼蝦,簡(jiǎn)單美味。今日便當(dāng):洋蔥炒牛肉和胡蘿卜炒木耳。牛肉粉干里面料還很充足,里面有洋蔥,黑木耳,香菇炒牛肉,孩子爸是百吃不厭,我著覺(jué)得油膩,兩次吃過(guò)就覺(jué)得膩了,還是覺(jué)得雞蛋肉...

竹瀝和鮮竹瀝的區(qū)別竹瀝和鮮竹瀝的區(qū)別有功效不同、主治不同等。1.功效不同:竹瀝具有清肺降火、滑痰利竅的功效;鮮竹瀝具有清熱化痰的功效。竹瀝水,由竹瀝油、白礬(細(xì)粉)組成。區(qū)別是,鮮竹瀝液功效更強(qiáng)...

硒是人體的生命之火,是人體內(nèi)不可缺少的營(yíng)養(yǎng)成分,生活中很多水果都含有硒元素,但你知道含硒第一名的水果是什么嗎?含硒高的水果又有哪些呢?跟水簇養(yǎng)生網(wǎng)一起來(lái)看看吧。...

一級(jí)夫妻性生活的年紀(jì)大概在20歲到50歲左右,如果是一種比較好的情況下,性生活的頻率一般在10到20分鐘左右,如果是比較差的夫妻,性生活的頻率可能會(huì)受到很多因素的影響,有些人可能會(huì)擔(dān)心,性生活的質(zhì)量不...

黃ba等中草藥可用于治療多種男科疾病。 可是不應(yīng)過(guò)多使用。 畢竟,該藥具有三點(diǎn)毒性,并且肯定會(huì)引起身體某些副作用,尤其是對(duì)腎功能的影響,將產(chǎn)生非常大的影響,因此一定應(yīng)該引起注意, 可能會(huì)繼續(xù)導(dǎo)致自...

三道鱗魚(yú)是歐美鯽魚(yú)的一種變異魚(yú),它在人體表面的鱗片很大。所以在歐洲的一些地區(qū),經(jīng)常有人用三道鱗魚(yú)來(lái)曬蝦米作為鏡子,所以三道鱗魚(yú)也有另外一個(gè)名字,鏡魚(yú)。如今,三道鱗魚(yú)已經(jīng)被引入中國(guó)許多地區(qū)進(jìn)行...

在我們的日常生活中,桂花酒屬于一種常見(jiàn)的酒,具有桂花樹(shù)的香味和多種營(yíng)養(yǎng)元素,特別適合冬季飲用。桂花酒可以暖身祛寒作用,還可以合理減少疲勞功效,改善睡眠質(zhì)量等。...

許多人喜歡在冬天去釣魚(yú)。在這種情況下,米酒通常被用作巢的材料。對(duì)于一些更有經(jīng)驗(yàn)的人來(lái)說(shuō),筑巢是非常好的。然而,許多人沒(méi)有做好并死去。死亡巢穴的出現(xiàn)有很多原因。可能是制作巢料時(shí)香料的味道太...

三角肌 注射是預(yù)防接種醫(yī)院門(mén)診的重點(diǎn)工作。精確定位和選擇合適的位置對(duì)于確保安全注射非常重要。三角肌注射/的正確方式是什么?三角肌宜注射方法是將右手收緊在部分皮膚上,將無(wú)名指固定在針上,使針...

我堅(jiān)信很多人都吃過(guò)馬鮫魚(yú),這是一種有價(jià)值的魚(yú),營(yíng)養(yǎng)含量很高,比如蛋白質(zhì)豐富多彩。另外,馬鮫魚(yú)含有維生素A和各種礦物質(zhì)元素。據(jù)了解,食用馬鮫魚(yú)具有補(bǔ)氣養(yǎng)血的功效,還具有止咳化痰的功效。女性可以通...

夏天很多人喜歡買(mǎi)泥鰍吃。泥鰍有很多做法,比如蒸、炸等等。它是一種人們非常喜歡吃的食物。而且泥鰍的營(yíng)養(yǎng)價(jià)值也很高,但是每次吃的時(shí)候處理掉泥鰍是個(gè)麻煩的問(wèn)題,尤其是如果內(nèi)臟需要清理的話(huà)。所以...

相信很多人都用過(guò)上海藥皂,它是中國(guó)上海第一塊特效除菌皂,那么上海藥皂都有什么作用呢?下面就來(lái)說(shuō)說(shuō)上海藥皂的功效與作用,一起來(lái)了解下吧。...





長(zhǎng)期吃小麥胚芽的好處有哪些?若長(zhǎng)期的食用對(duì)人體有什么危害嗎?

星鯊維生素d3滴劑曝光的相關(guān)信息,看完能正確問(wèn)題

童年時(shí)光鈣鎂鋅副作用,會(huì)給孩子帶來(lái)什么困擾?

關(guān)于過(guò)度疲勞的十大癥狀有哪些?你知道嗎

細(xì)胞生長(zhǎng)肽(細(xì)胞生長(zhǎng)肽的功效與作用)
